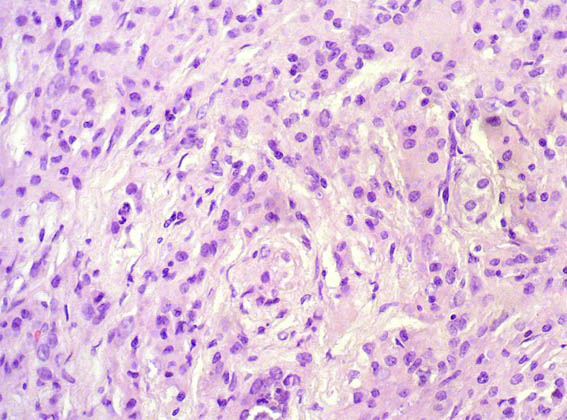

|
|
CASE
129 (November 2016)
Clinical information
The patient is a 67-year-old woman with renal mass that completely replaced the left kidney. No lithiasis.
Nephrectomy was done.

Figure 1.

Figure 2.

Figure 3. H&E, X100.
Figure 4. H&E, X400.

Figure 5. H&E, X200.

Figure 6. PAS, X400.

Figure 7. Von Kossa staining, X200.
What is your diagnosis?
See
diagnosis and discussion
[Top]
|
|